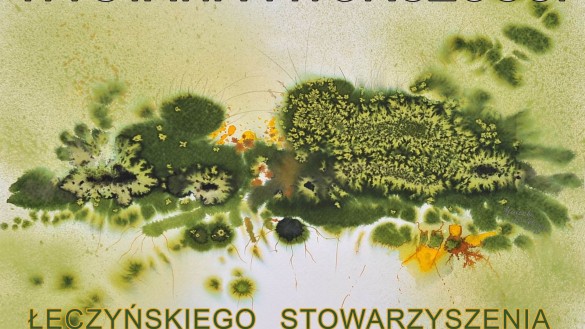

Miejski Ośrodek Kultury (Galeria „Hall”, ul. Radomska 1) w Pionkach zaprasza w piątek 29 kwietnia o godz. 18.00 na wystawę twórczości Łęczyńskiego Stowarzyszenia Twórców Kultury i Sztuki „Plama”.
W 1983 roku z inicjatywy Osiedlowego Domu Kultury w Łęcznej zawiązała się paczka pasjonatów ukazujących piękno świata różnorodnymi środkami malarskimi. Ta nieformalna grupa przez lata promowała upowszechnianie kultury plastycznej w środowisku. W 2004 roku przyjęła status stowarzyszenia i dała początek działalności łęczyńskiemu stowarzyszeniu twórców kultury i sztuki „Plama”.
W dorobku ma ono szereg wystaw zbiorowych w Polsce, jak również na Białorusi, Węgrzech, Ukrainie, we Włoszech, Francji oraz udział członków w plenerach międzynarodowych i licznych indywidualnych wystawach w galeriach w kraju i poza jego granicami. „Plama” była organizatorem wielu lokalnych konkursów plastyczno-fotograficznych i Ogólnopolskiego Konkursu Rysunku Węglem. Jest współinicjatorem międzynarodowych plenerów artystycznych, na które od 2005 roku przybywają artyści z odległych zakątków naszego globu. Stowarzyszenie ma swoim koncie wiele warsztatów poetyckich oraz publikacji: almanachy poetyckie, dwa tomy „Łęcznian”, zbiory opowiadań z serii „Łęczyńskie wspomnienia” oraz cykl albumów fotograficznych „Pamięć miejsc”. Było też realizatorem przedstawień scenicznych oraz występów teatru tancerzy ognia.
Za te kulturotwórcze działania zostało wyróżnione prestiżową Nagrodą Burmistrza Łęcznej „Łęczyński Odyniec Kultury 2002”, a w 2013 roku Minister Kultury i Dziedzictwa Narodowego przyznał „Plamie” honorową odznakę „Zasłużony dla Kultury Polskiej”.
Aktualnie grupa zrzesza nie tylko artystów z Łęcznej, lecz także z innych miast Polski. Wielu należy do innych organizacji twórczych m.in. Związku Polskich Artystów Plastyków, Towarzystwa Przyjaciół Sztuk Plastycznych w Lublinie czy Polskiego Stowarzyszenia Nauczycieli Plastyków.
Każdego roku ekspozycja składająca się z nowej kolekcji obrazów, grafik, fotografii, rzeźby prezentowana jest w łęczyńskiej galerii, a następnie wędruje do innych zaprzyjaźnionych galerii województwa lubelskiego i dalej w Polskę. Pionki to kolejne miasto na tym szlaku. Autorami prezentowanych na wystawia prac są: Żaneta Kowalska, Agnieszka Wróblewska, Ula Sawiuk, Arkadiusz Kulpa, Renata Szuryga, Paweł Brodzisz, Maryla Giszczak, Agnieszka Bydlińska, Urszula Bydlińska, Teresa Pietras, Marzena Malinowska, Małgorzata Ostasz, Krzysztof Zuzański, Maria Majka Zuzańska, Stanisław Andrzej Winiarski, Dorota Bogucka, Krzysztof Olszak, Marta Siwko, Krystyna Mojska, Stanisława Kotarska, Katarzyna Jagiełło, Teresa Stasiak, Maryla Małecka, Rafał Dybich, Urszula Wójcik, Magdalena Mańkowska i Barbara Zielińska.
(TO-RT)
Źródło: mok.pionki.pl